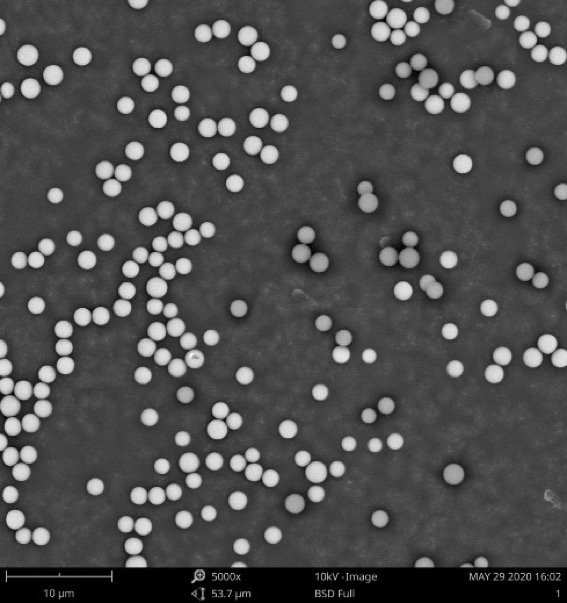

在粉体工业领域中,粉体表面的包覆改性工艺是提升产品使用性能的重要方法,对于粉体改性来说,包覆率是关键的参数,但目前主要采用间接考察和检测的方法获得,主要方法如下:
1.采用扫描电镜结合能谱的方式、/span>包覆与否的颗粒表面元素种类及含量是不一样的,因此可以通过该方式观察样品包覆情况,但是其缺点是无法自动统计,只能观察微小区域的颗粒,结果较为片面;
2.采用热重分析方法、/span>比如硬脂酸包覆碳酸钙,如果硬脂酸跟碳酸钙只是普通的物理混合,那么热重分析只有两个峰,一旦硬脂酸跟碳酸钙有作用,他的分解温度就会发生变化,可能就会出现三个峰,一个碳酸钙,一个硬脂酸,还有一个介于两者之间,就是硬脂酸跟碳酸钙结合的部分,这样可以根据这部分分解温度和含量来考察包覆,该方法结果较为准确,但是实验周期长:/p>
3.XPS是另外一种分析材料表面的方法,信号来源厚 ?0nm,对于材料表面可以有非常灵敏的响应,可以显示出材料表面的元素信息,并依据得到的谱图上对应峰面积进行半定量分析。但是应用于粉体包裹率计算,信号来源浅,误差大,测试效率低、/p>

颗粒统计分析测量系统
高清的颗粒图像,高效的处理速度,准确的统计结果,看似矛盾的工作,对于飞纳电镜来说就变得轻而易举。那么,飞纳电镜是如何做到的呢?
1. 飞纳电镜高亮 CeB6灯丝
首先,高亮度灯丝是扫描电镜进行图像分析的核心。当灯丝亮度充足时,不同元素才能够展现出更好的衬度,简而言之就是更容易分辨出颗粒是否被包覆、/p>
2. Nebula 颗粒分散系统
其次,颗粒分散制样,是对样品进行准确分析统计的先决要求,如果颗粒出现大量的堆积、团聚,将大大降低统计的准确性。如何解决颗粒分散问题呢?飞纳采 Nebula 颗粒分散系统,效果如下图所示,分别为采 Nebula 颗粒分散器和手工分散的样品,可以直观的看出,手工分散的材料存在大量团聚、覆盖的现象,而采 Nebula 分散的样品,颗粒分布均匀,无明显的团聚。在此基础上我们对样品进行统计分析、/p>

手动分散的材斘/p>
Nebula 颗粒分散器分散的材料
然后,通过颗粒分析系统对样品进行数据采集分析,可轻松识别颗粒,并获取等效直径、长短径、周长、面积、圆度等颗粒信息,如 1 所示、/p>

?. 颗粒统计信息
那么重点来了,飞纳如何做到颗粒包覆与否的判断呢?我们不妨从电镜图片中寻找线索。如 2 所示,从颗粒的明暗程度就可以看出,偏亮的颗粒具有较高的灰度,偏暗的颗粒(红色框标注)具有较低的灰度。通过能谱(图 3)进一步验证了灰度低的颗粒为原始颗粒,而灰度高的颗粒为成功包覆 Au 颗粒的物料,因此,通过灰度值就能够轻松判断包覆效果、/p>

? 颗粒扫描电镜国/p>

? 颗粒能谱分析
然后通过颗粒统计分析软件对识别到的所有颗粒按照灰度值进行统计分布,一键便可得到如 4 所示分布图,通过简单的对比,可以判定出灰度值小 185 的颗粒属于未包覆成功的,同时从数量百分比曲线可以读出,灰度值小 185 的颗粒所占比?3%,那么包覆成功的颗粒占到 87%?-13%)。至此,飞纳电镜轻松完成包覆率统计工作、/p>

4 颗粒统计分布
飞纳电镜颗粒系统主要用于统计颗粒样品尺寸信息的统计,但是通过思维发散,我们便可以用之统计颗粒包覆率。因此,大可不必拘泥于产品的固定功能,发挥想象,飞纳电镜能为您创造更多可能性!
2926
0
- EVA型热熔胶书刊装订强度检测与质量控制研究
- 自动热压机的发展趋势是怎样的?
- 用户论文 ▏化学吸 ▏铱-铼共沉积乙醇处理后SiO2载体催化剂应用在甘油氢解反应
- 为什么近期单壁碳纳米角(CNH)的研究进展值得关注>/a>
- 为什么介孔SiO2在药物递送领域的应用越来越多>/a>
- FRITSCH飞驰球磨——不锈钢介导的水中球磨条件下定量H2生成实验研究
- 为什么MoS2在催化领域的研究进展值得关注?
- 飞纳台式扫描电镜助力纳米纤维在心血管组织再生中的研穵/a>
- 磷酸化修饰鬼臼果多糖的制备及生物活?/a>
- DSR论文解读:Advanced Science News 报道中科院长春应化所新型非铂催化材料研究成果
- High-throughput preparation, scale up and solidification of andrographolide nanosuspension using hummer acoustic resonance technology(纳米混悬剂制备的前瞻性技 - 蜂鸟声共振)
- 扫描电镜优秀论文赏析|飞纳台式扫描电镜电极材料上的应?/a>
- 扫描电镜论文赏析-干旱影响杨树叶片及次生木质部发育的分子机刵/a>
- 压实度与密实度的区别
- 振实密度和压实密度的关系
- 勃姆石专用气流粉碎机分级机打散机

